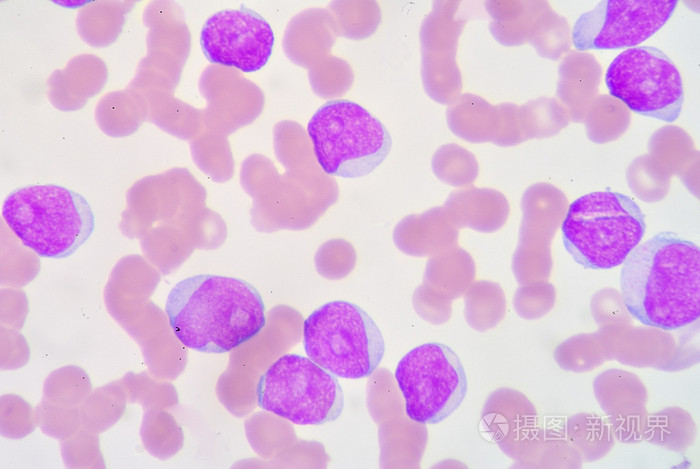
淋巴细胞增多

原始淋巴细胞

原始淋巴细胞 18
图片尺寸650x484
原始粒细胞 原始淋巴细胞 原始单核细胞
图片尺寸1080x810
可见两个淋巴细胞,多个原始细胞,其中两个存在胞核内陷(杯口细胞)外周
图片尺寸1000x954
急性淋巴细胞白血病
图片尺寸716x540
淋巴细胞增多
图片尺寸700x469
外周血涂片#淋巴细胞白血病
图片尺寸672x1089
▼「原始淋巴细胞」形态特征:细胞胞体呈圆形,核染色质细致,可见核仁
图片尺寸750x1000
各种淋巴细胞及其它细胞
图片尺寸2000x2666
第9章b淋巴细胞ppt
图片尺寸1080x810
p>淋巴细胞(lymphocyte)是白细胞的一种,是体积最小的白细胞.
图片尺寸649x434
淋巴细胞的分类
图片尺寸500x328
淋巴细胞
图片尺寸1100x1146
各种淋巴细胞及其它细胞
图片尺寸2000x2666
各种淋巴细胞及其它细胞
图片尺寸2000x2666
外周血涂片#淋巴细胞白血病
图片尺寸511x810
戊肝后淋巴细胞增多原因万万想不到
图片尺寸503x400
p>淋巴细胞(lymphocyte)是白细胞的一种,是体积最小的白细胞.
图片尺寸575x379
镜检结果:原始 幼稚细胞 42%↑,淋巴细胞 27%,中性粒细胞 20%↓,单核
图片尺寸563x675
红细胞,血红蛋白及血小板基本正常,血片可见大量原始及幼稚淋巴细胞约
图片尺寸639x545
(说明:外周血涂片报告中原始和幼稚淋巴细胞并不会严格区分,统一报告
图片尺寸1080x1439